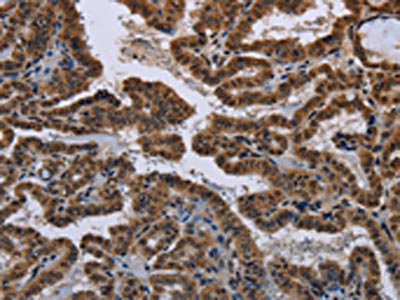

-
中文名稱:MYCN兔多克隆抗體
-
貨號:CSB-PA965036
-
規格:¥1100
-
圖片:
-
The image on the left is immunohistochemistry of paraffin-embedded Human thyroid cancer tissue using CSB-PA965036(MYCN Antibody) at dilution 1/50, on the right is treated with synthetic peptide. (Original magnification: ×200)
-
The image on the left is immunohistochemistry of paraffin-embedded Human brain tissue using CSB-PA965036(MYCN Antibody) at dilution 1/50, on the right is treated with synthetic peptide. (Original magnification: ×200)
-
-
其他:
產品詳情
-
Uniprot No.:
-
基因名:
-
別名:bHLHe37 antibody; Class E basic helix-loop-helix protein 37 antibody; MODED antibody; mycn antibody; MYCN_HUMAN antibody; N myc antibody; N myc proto oncogene protein antibody; N-myc proto-oncogene protein antibody; Neuroblastoma derived v myc avian myelocytomatosis viral related oncogene antibody; Neuroblastoma MYC oncogene antibody; NMYC antibody; NMYC proto oncogene protein antibody; ODED antibody; Oncogene NMYC antibody; pp65/67 antibody; V myc avian myelocytomatosis viral oncogene neuroblastoma derived homolog antibody; v myc avian myelocytomatosis viral related oncogene neuroblastoma derived antibody; v myc myelocytomatosis viral related oncogene neuroblastoma derived antibody
-
宿主:Rabbit
-
反應種屬:Human,Mouse,Rat
-
免疫原:Synthetic peptide of Human MYCN
-
免疫原種屬:Homo sapiens (Human)
-
標記方式:Non-conjugated
-
抗體亞型:IgG
-
純化方式:Antigen affinity purification
-
濃度:It differs from different batches. Please contact us to confirm it.
-
保存緩沖液:-20°C, pH7.4 PBS, 0.05% NaN3, 40% Glycerol
-
產品提供形式:Liquid
-
應用范圍:ELISA,IHC
-
推薦稀釋比:
Application Recommended Dilution ELISA 1:2000-1:5000 IHC 1:50-1:200 -
Protocols:
-
儲存條件:Upon receipt, store at -20°C or -80°C. Avoid repeated freeze.
-
貨期:Basically, we can dispatch the products out in 1-3 working days after receiving your orders. Delivery time maybe differs from different purchasing way or location, please kindly consult your local distributors for specific delivery time.
-
用途:For Research Use Only. Not for use in diagnostic or therapeutic procedures.
引用文獻
相關產品
靶點詳情
-
功能:Positively regulates the transcription of MYCNOS in neuroblastoma cells.
-
基因功能參考文獻:
- TBX2 is a neuroblastoma core regulatory circuitry component enhancing MYCN/FOXM1 reactivation of DREAM targets. PMID: 30451831
- This suggested that NMyc regulated survival and growth of CHP134 and BE2C neuroblastoma cells, potentially through Wnt/betacatenin signaling. Furthermore, associated proteins, NMyc and STAT interactor and dickkopf Wnt signaling pathway inhibitor 1, were demonstrated to be involved in this regulation. PMID: 29749516
- In this report, we present a case with Feingold Syndrome having a novel mutation in MYCN gene and discuss genetic counselling and prenatal diagnosis due to pregnancy of the patient's mother. PMID: 30204967
- Results demonstrated that MYCN expression was downregulated in cholangiocarcinoma (CCA) through a mechanism involving miR-5095 binding its 3'UTR. PMID: 29620172
- MYCN levels are regulated transcriptionally by MYCNOS-01 (an alternative transcript of MYCNOS) in rhabdomyosarcoma and neuroblastoma cells. PMID: 29466962
- a MycN/CIP2A-mediated cell-fate bias may reflect a possible mechanism underlying early priming of some aggressive forms of neuroblastoma. PMID: 30021854
- CD133 expression and MYCN amplification induce chemoresistance and reduce average survival time in pediatric neuroblastoma. PMID: 29322842
- Data indicate that inter-play between MYCN and the highly tumorigenic proteins which are upregulated in the malignant IMR-32 neuroblastoma cells may be fueling their aggressive behavior. PMID: 29328367
- these results suggest that MYCN serves as a prognostic biomarker and therapeutic target of ACR for liver cancer stem cell in de novo Hepatocellular carcinoma. PMID: 29686061
- Alternative nonhomologous DNA end-joining pathway proteins as components of MYCN oncogenic activity in human neural crest stem cell differentiation have been revealed in the process of neuroblastoma initiation in mice. PMID: 29238067
- High TrkA expression is one of the most powerful predictor of good prognosis in neuroblastoma and is associated with younger age, lower stage, and absence of MYCN amplification PMID: 29018959
- overexpression of MYCN promoted cell proliferation, and induced erythroid differentiation block and apoptosis resistance to cytotoxic agent. Knockdown of MYCN inhibited the expression of EZH2, and then activated p21 expression through removal of H3K27me3 at the p21 promoter. PMID: 29022893
- MAX to MYCN ratio that can account for tumour progression and clinical outcome in neuroblastoma. PMID: 29408445
- MYCN expression is regulated by ZAR1 in neuroblastoma. PMID: 28791558
- The target of miR-29b was predicted using miRanda, TargetScan and PicTar sofeware and authors also found MYCN was a direct target of miR-29b in glioma cells and miR-29b inhibited the proliferation of glioma cells via MYCN dependent way. PMID: 28423357
- eEF2K protects MYCN overexpressing NB cells from ND in vitro and in vivo, highlighting this kinase as a critical mediator of the adaptive response of MYCN amplified NB cells to metabolic stress. PMID: 28574509
- Among 30 samples of brain tumor, 14 cases revealed MYCN amplification. High-protein expression of MYCN was also observed in 43.3% of patients. There was a significant correlation between MYCN gene amplification and protein expression, interestingly five case showed discrepancy between the gene amplification and protein expression. PMID: 28453467
- PRMT1 has a role in regulating MYCN in neuroblastoma PMID: 27571165
- N-myc levels appear to be modulated by the antagonistic interactions of both miR-17, as a negative regulator, and HuD, as a positive regulator in N-myc-amplified neuroblastoma cells. PMID: 28560387
- We also propose a model for the stabilization mechanism in which binding to Aurora-A alters how N-Myc interacts with SCF(FbxW7) to disfavor the generation of Lys48-linked polyubiquitin chains PMID: 27837025
- This study provides a novel insight for miR-221 in the control of neuroblastoma cell proliferation and tumorigenesis, suggesting potentials of miR-221 as a prognosis marker and therapeutic target for patients with MYCN overexpressing neuroblastoma. PMID: 28003306
- N-MYC is in the downstream-regulated gene family in reprogramming cancer metabolism under hypoxia [review] PMID: 27447861
- SNHG1 is up-regulated by MYCN amplification and could be a potential prognostic biomarker for high-risk neuroblastoma intervention. PMID: 27517149
- MYCN expression is a marker indicative of likely clinical sensitivity to mTOR inhibition in neuroblastoma cells PMID: 27438153
- Results show that MYCN and LSD1 co-localize at NDRG1 promoter and repress its expression in neuroblastoma cells. PMID: 27894074
- Data indicate cross-talks between MYCN and beta-catenin signalling, which repress normal beta-catenin mediated transcriptional regulation. PMID: 27531891
- Data show that transcription factor activating enhancer binding protein-4 (TFAP4) is a direct transcriptional target of MYCN in neuroblastoma and that high levels of this transcription factor are associated with poor clinical outcome in this disease. PMID: 27448979
- data extend knowledge on roles of MCPIP1 in our model and link the protein to regulation of expression and stability of MYCN through decrease of signaling via Akt/mTOR pathway. PMID: 27935099
- Data show that MYCN and its regulated microRNAs acted together to repress the tumor suppressor genes. PMID: 27167114
- Common genetic variation predisposes to different neuroblastoma genotypes, including the likelihood of somatic MYCN-amplification. [meta-analysis] PMID: 29117357
- Results establish evidence that high MYCN amplification can be present in retinoblastoma with or without coding sequence mutations in the RB1 gene. PMID: 28211617
- The study conducted metabolic profiling of pre-malignant sympathetic ganglia and tumors derived from the TH-MYCN mouse model of neuroblastoma, that overexpresses human MYCN and compared to non-malignant ganglia from wildtype littermates. These results identify enhanced glutathione biosynthesis as a selective metabolic adaptation required for initiation of MYCN-driven neuroblastoma. PMID: 26996379
- Many prognostic signatures for neuroblastoma are confounded by MYCN amplification. PMID: 27599694
- Increasing MYCN copy number is associated with an increasingly higher rate of unfavorable clinical/biological features, with 11q aberration being an exception. Patients with MYCN gain appear to have inferior outcomes, especially in otherwise more favorable groups. PMID: 28696504
- miR-21 enhances chemo-resistance in tongue cancer cells via directly targeting CADM1, and an inverse correlation between miR-21 and CADM1 expression in vivo. MiR-21 overexpression is attributed to MYCN-mediated transcriptional regulation, which is also predictive for a worse prognosis in tongue cancer PMID: 27055844
- LMO1 is an important oncogene that promotes neuroblastoma initiation, progression, and widespread metastatic dissemination. PMID: 28867147
- our results identify DOT1L as a novel cofactor in N-Myc-mediated transcriptional activation of target genes and neuroblastoma oncogenesis. Furthermore, they characterize DOT1L inhibitors as novel anticancer agents against MYCN-amplified neuroblastoma. PMID: 28209620
- CCCTC-binding factor (CTCF) targets the binding sites within MYCN promoter to facilitate its expression in neuroblastoma (NB) cells. PMID: 26549029
- PAX3-FOXO1 collaborates with MYCN during early rhabdomyosarcoma (RMS) tumourigenesis to dysregulate proliferation and inhibit myogenic differentiation and cell death. PMID: 28138962
- The findings reveal a PLK1-Fbw7-Myc signaling circuit that underlies tumorigenesis and validate PLK1 inhibitors, alone or with Bcl2 antagonists, as potential effective therapeutics for MYC-overexpressing cancers. PMID: 27773673
- Results show that N-Myc overexpression leads to the development of poorly differentiated, invasive prostate cancer that is molecularly similar to human NEPC. PMID: 27728805
- Rac activity may be an important determinant of metastatic capability in subsets of neuroblastoma cells lacking MYCN amplification. PMID: 27224546
- MYCN Gene Amplification is associated with Neuroblastoma. PMID: 27513929
- MYCN overexpression combined with activated anaplastic lymphoma kinase (ALK) is sufficient to induce neuroblastoma (NB) in mouse sympathoadrenal cells PMID: 27707976
- MYCN amplification can be heterogeneous between tumor sites, during tumor progression or following treatment, challenging the notion that MYCN copy number does not change for a particular neuroblastoma. PMID: 27465929
- High MycN expression is associated with low radiosensitivity in neuroblastoma. PMID: 27432152
- applying loss-and-gain function analysis, we demonstrated that miR-34a directly targeted to MYCN to sensitize NSCLC cells to cisplatin. In addition, p53 was found to monitor the expression of miR-34a in NSCLC cells after cisplatin treatment. Therefore, the sensitivity of cisplatin in NSCLC cells was modulated via p53/miR-34a/MYCN axis. PMID: 27836543
- Data supports our hypothesis that a positive-feedback loop of sonic hedgehog signaling induced INSM1 through N-myc and INSM1 enhanced N-myc stability contributing to the transformation of human neuroblastoma. PMID: 26456864
- Data show that v-myc avian myelocytomatosis viral oncogene neuroblastoma derived homolog (MYCN) was overexpressed in non-small cell lung cancer (NSCLC) tumor tissues and cell lines, suggesting that targeting MYCN might provide beneficial effects for the clinical therapy of NSCLC. PMID: 27449038
- That initial decision to deny coverage could have had untoward health implications for this child, as the identification of constitutional MYCN duplication necessitated surveillance imaging for a number of pediatric malignancies associated with MYCN PMID: 27794475
顯示更多
收起更多
-
相關疾病:Feingold syndrome 1 (FGLDS1)
-
亞細胞定位:Nucleus.
-
組織特異性:Expressed in the neuronal cells of the cerebrum, neuroblastomas and thyroid tumors (at protein level).
-
數據庫鏈接:
Most popular with customers
-
-
YWHAB Recombinant Monoclonal Antibody
Applications: ELISA, WB, IHC, IF, FC
Species Reactivity: Human, Mouse, Rat
-
Phospho-YAP1 (S127) Recombinant Monoclonal Antibody
Applications: ELISA, WB, IHC
Species Reactivity: Human
-
-
-
-
-